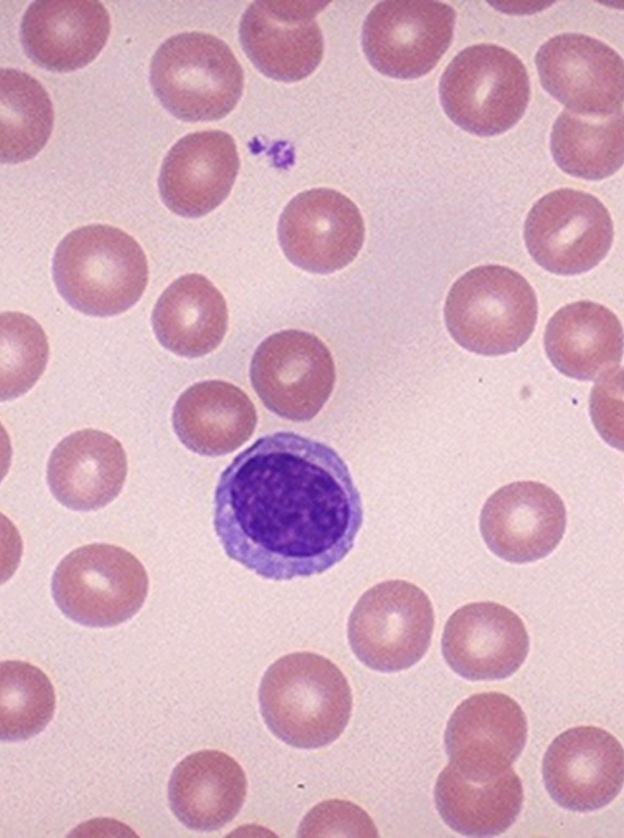
Microscopic view of a lymphocyte

Cadastre-se para desbloquear mais recursos
- Salve este baralho na sua conta
- Estude flashcards com repetição espaçada
- Exportar para Anki (.apkg) ou PDF
- Processar documentos de até 100 páginas
- Imagens extraídas de PDFs e documentos
- Extração de texto melhorada em seus PDFs e documentos
- Flashcards melhores com nosso modelo de IA mais avançado
Flashcards neste baralho (213)
-
pathogens bacteria
-
bacteria properties
-
bacteria reproduction
-
If bacteria have unlimited food and reproduce every 20 minutes, how often do they reproduce?
Every 20 minutes.
bacteria reproduction -
What is the approximate number of bacteria after 24 hours with unlimited reproduction?
- \(2.5\times10^{21}\)
- 2,500,000,000,000,000,000,000
bacteria exponential -
bacteria microscopy
-
microbiology bacteria
-
microbiology growth
-
microbiology bacteria growth
-
microbiology bacteria growth
-
immunology virology cells
-
virology virus particles
-
protists malaria pathogens
-
rbc protists pathology
-
trypanosomes sleepingsickness protists
-
How do the trypanosoul protists interact with red blood cells according to the notes?
- They live inside and consume RBC
 trypanosomes rbc infection
trypanosomes rbc infection -
pathogens fungi
-
pathogens fungi ocr
-
pathogens animals
-
chigger bites
-
chigger blood
-
Which two single-word terms related to reproduction or life stage appear after 'use blood'?
- female
- egg
life-cycle terms -
reaction allergy
-
What happens to bacteria that land on intact skin?
Skin covers the bacteria so it flows off the surface.
immunity skin innate -
What is a key structural feature of the outermost layer of skin relevant to defense?
The outer layer is composed of dead cells that present to the outside world.
skin barrier innate -
How does the skin remove microbes attached to its surface?
Skin continually sheds dead cells, which helps remove microbes.
skin defense innate -
Which image shows a cross-section of skin including dead outer cells?

The image illustrates the skin cross-section with dead outer cells.
skin image anatomy -
What does the microscopic view of skin pores demonstrate about bacteria on skin?

It shows bacteria present on the skin surface where they can be shed or flow off.
skin microbiology innate -
immunity barriers
-
What is a key cellular property of mucus membranes?
Mucus membranes are composed of living cells that are exposed to the outside environment.
mucus membranes -
How does mucus help prevent infection?
Mucus is sticky, which traps bacteria and other particles to prevent them from reaching tissues.
mucus function -
Name three common effects or consequences of mucus in the nasal/oral cavities.
- Runny nose
- Post-nasal drip
- Sore throat
 symptoms mucus
symptoms mucus -
immunity innate defenses
-
What role do tears play in nonspecific immune defense of the eye?
Tears are a complex fluid containing antibiotic-type molecules that constantly wash pathogens off the eyes.
immunity eye tears -
Name two anatomical structures of the lacrimal system involved in tear drainage.
- Lacrimal sac
- Nasolacrimal duct
anatomy lacrimal eye -
Where do tears drain via the nasolacrimal duct according to the notes?
Tears are sent through the nasolacrimal duct to flush into the stomach.
lacrimal drainage eye -
What phrase in the notes describes the continuous action of the lacrimal system?
A 'sheet of tears always works' to flush the eye.
lacrimal function eye -
What are common nonspecific physical barriers that help prevent infection?
- Skin
- Mucus
- Tears
- Stomach acid
immunity barriers innate -
What effect does stomach acid have on pathogens?
- Stomach acid deactivates pathogens
- Many pathogens cannot survive in stomach acid
 stomach immunity innate
stomach immunity innate -
What happens to post-nasal drip and other swallowed material in relation to stomach acid?
- All swallowed post-nasal drip is exposed to stomach HCl
digestion immunity innate -
What are examples of nonspecific physical barriers to infection?
- Skin
- Mucus
- Tears
- Stomach acid
- Ear wax
immunity innate barriers -
ear wax barriers
-
mucus innate barriers
-
Name major external and middle ear structures listed in the diagram.
- Pinna
- External Auditory Canal
- Tympanic Membrane (eardrum)
- Malleus
- Semicircular Canals
- Cochlea
- Eustachian Tube
 ear anatomy diagram
ear anatomy diagram -
immunity phagocytosis cells
-
immunity pathogens
-
Into which body conduits or sites are phagocytic cells funneled?
They are funneled into lymphatic vessels & nodes and blood.
lymphatic circulation -
Give one observable action of phagocytic white blood cells during an immune response.
They engulf bacteria.
 immunity visual
immunity visual -
How does a phagocytic white blood cell ingest bacteria?
They take bacteria into their own cell inside a vesicle (phagosome).
immunity phagocyte cells -
What do phagocytic white blood cells secrete into the vesicle to digest ingested material?
They secrete digestive enzymes into the vesicle.
immunity enzymes phagocyte -
What happens to material after a phagocytic white blood cell digests it?
The breakdown products are used as a food source by the cell.
immunity metabolism phagocyte -
Illustration of a phagocytic white blood cell engulfing bacteria (image as supplementary on answer side).

- This image shows a white blood cell surrounding bacteria in a vesicle.
immunity image phagocyte -
What substance do damaged cells release that makes blood vessels leaky during inflammation?
Histamine
inflammation histamine -
inflammation function
-
inflammation phagocytes
-
Why does tissue swelling occur during inflammation?
Vessels become leaky, allowing fluid to move into the area
inflammation swelling -
inflammation pus
-
inflammation signals
-
antihistamine medication
-
Name an environmental trigger mentioned that can cause an inflammatory/allergic response without bacteria.
Pollen
allergy triggers -
Which diagram illustrates phagocytes and fluid moving into an inflamed area? (see answer for image)
Phagocytes and fluid move into the area during inflammation.
 inflammation diagram
inflammation diagram -
What is the role of interferons in viral infection?
They act as a warning signal to other cells of viral attack.
immunity interferons innate -
How do interferons affect killer cells and infected self cells?
They activate killer cells which then cover and kill self cells affected.
immunity interferons killercells -
What is the function of the complement system against pathogens?
It cuts holes in pathogens' cell membranes.
immunity complement innate -
Illustration: which antimicrobial molecule inserts into a foreign cell membrane to create a hole?
The complement molecule inserts into a foreign cell membrane to create a hole.
 immunity complement diagram
immunity complement diagram -
Illustration: which molecule is shown being released by a virus as a warning signal?
Interferons are shown being released by a virus as a warning signal.
 immunity interferons diagram
immunity interferons diagram -
immunity fever definition
-
immunity fever function
-
immunity fever pathogens
-
What are 'specific defenses' in the immune system?
Defenses that provide recognition and defense against specific pathogens.
immunity adaptive -
How do the immune system identify viruses and other pathogens?
By molecules exposed on the pathogen's surface that are used to identify the pathogen.
antigen recognition -
Name two requirements for effective specific (adaptive) immunity.
- 'Self vs non-self' recognition
- 'Immunity memory' (the body remembers pathogens for a rapid response).
adaptive memory -
How does vaccination relate to immune memory?
Vaccination creates immune memory so the body can mount a rapid response to pathogens it has previously encountered.
 vaccination memory
vaccination memory -
immunity antigens
-
immunity recognition
-
immunity memory
-
immunity proteins
-
Which bacterial structures are associated with these antigen types?
- Flagellum: H antigens
- Cell wall: O antigens
- Pili: F antigens
- Capsule: K antigens
bacteria antigens -
immunity recognition
-
antigen immunity
-
antibody immunity
-
What do antibodies do to antigenic molecules?
Antibodies stick to antigenic molecules (they bind to specific antigens).
 antibody binding
antibody binding -
What is neutralization by antibodies?
- Antibodies stick to antigens
- Antigen cannot land on receptor
- Prevents pathogen from entering human cell
immunity neutralization -
How do antibodies prevent SARS-CoV-2 from infecting a human cell (illustrated)?
Antibodies bind to viral antigens so the antigen cannot bind receptors on the human cell, preventing entry.
immunity sars-cov-2 antibodies -
immunity image
-
What is the primary function of lymph nodes in the lymphatic system?
They filter body fluids and destroy pathogens.
lymphatic immunity -
What happens to lymph fluid after it is filtered by lymph nodes?
It is returned to circulation (plasma returned into the bloodstream).
lymphatic circulation -
What type of fluid do lymph nodes filter?
They filter interstitial fluid that leaks out of blood vessels into lymphatic ducts.
lymphatic fluids -
Which cell type in lymph nodes consumes and kills pathogens?
Macrophages consume and kill pathogens.
cells macrophage -
Why do lymph nodes often become swollen when a person is sick?
Because white blood cells and immune activity increase as pathogens are filtered and destroyed.
symptom lymphnode -
How can the lymphatic system contribute to pathogen spread within tissues?
Interstitial fluid can distribute pathogens through lymphatic routes.
pathogen spread -
View an illustrative cross-section of a lymph node showing fluid flow. What does this image help explain about lymph node function?
It illustrates how lymph flows through nodes for filtering; macrophages and WBCs encounter pathogens during that flow.
 visual lymphnode
visual lymphnode -
What is the primary role of lymph vessels and lymph nodes in the lymphatic system?
They carry lymphatic fluid to structures such as lymph nodes.
lymphatic anatomy -
What is the main function of macrophages?
Macrophages are phagocytic cells that ingest and remove pathogens and debris.
macrophage innate -
What is the primary function of lymphocytes?
Lymphocytes make antibodies as part of adaptive immunity.
lymphocyte adaptive -
How is a lymphocyte commonly depicted microscopically?
- Microscopic view of a lymphocyte often shows a single, round cell among red blood cells
lymphocyte image
lymphocyte image -
lymphocytes immunology
-
lymphocytes immunology
-
tcells immunology
-
antibodies genetics
-
antibodies immunology
-
List the labelled components of an antibody molecule shown in the diagram.
- Heavy chain
- Light chain
- Variable portion
- Constant portion
- Disulphide bond
- Antigen-binding sites
 antibodies structure
antibodies structure -
antibodies bcells
-
What is the primary immune response?
The immune response that occurs the first time a pathogen is encountered.
immunity primary -
What recognition is required for the primary immune response to occur?
Recognition of self/non-self.
immunity recognition -
Which respiratory action produces the greatest number of droplets?
- Sneezing produces the greatest number of droplets (~40,000).
 droplets respiratory
droplets respiratory -
What key requirement does the primary immune response need to occur?
Recognition of self versus non-self.
immunity recognition -
exposure pathogens sneeze
-
masks publichealth
-
droplets transmission
-
Which mask types are shown in the droplet-spread comparison?
- No Mask
- 1 Layer Cloth Covering
- 2 Layer Cloth Covering
- Surgical Mask
masks comparison -
media image
-
During a sneezing event, what does the expelled cloud predominantly contain?
- Turbulent gas cloud predominantly with aerosols
- Large droplets
aerosols sneezing -
During a coughing event, what does the expelled cloud predominantly contain?
- Turbulent gas cloud predominantly with aerosols
- Large droplets
aerosols coughing -
During exhaling, what does the exhaled air predominantly contain?
- Exhaled air predominantly with aerosols
- Large droplets
aerosols exhaling -
What particle types are present at 1 m from an infected person without any mask?
- Aerosols
- Large droplets
 masks aerosols
masks aerosols -
immunology apc
-
immunology macrophage
-
immunology antigens
-
List the main steps a macrophage uses to remove a pathogen.
- Put out pseudopodia
- Surround and engulf in a vesicle
- Digest the pathogen
immunology phagocytosis -
immunology macrophage
-
How do macrophages activate helper T-cells?
- By presenting surface antigen
- By secreting Interleukin-1
immunology macrophage helpert -
immunology cytokine il-1
-
What actions do helper T-cells perform after activation by macrophages?
- Prime the immune response
- Talk to other cells
- Communicate identity to other parts of the immune system
 immunology helpert functions
immunology helpert functions -
What role does antigen presentation by macrophages serve in helper T-cell activation?
It communicates pathogen identity to helper T-cells via a surface antigen
immunology antigen macrophage -
immunology tcells cytokines
-
Name two primary actions of helper T-cells.
- Stimulate B-cells to make antibodies by secreting interleukin-2
- Activate killer T-cells (cytotoxic T cells)
immunology tcells functions -
immunology tcells cytotoxic
-
immunology tcell cytotoxic
-
How do cytotoxic T-cells act on infected target cells according to the notes?
They bind to infected target cells and kill the infected cells by releasing perforin.
mechanism perforin immune -
Name a molecule released by cytotoxic T-cells that is associated with killing infected cells.
- Perforin
 perforin visual tcell
perforin visual tcell -
immunology tcell cytotoxic
-
Which protein do cytotoxic T-cells release to create pores in an infected target cell's membrane?
Perforin
immunology perforin mechanism -
How do perforin molecules contribute to killing an infected cell?
They form pores in the target cell membrane, leading to the infected cell's death.
 immunology perforin diagram
immunology perforin diagram -
What is the primary function of suppressor T-cells?
Inhibit the activity of T-cells and B-cells once infection is under control
immunology tcells adaptive -
immunology regulation
-
According to the notes, what happens to antibody levels if suppressor T-cells are killed?
Not a lot of antibodies
immunology antibodies -
What is clonal selection in B-cell immunity?
Selection of B cells that bind a specific antigen (many different B-cell kinds) leading those antigen-binding cells to become activated.
immunology clonal_selection bcells -
anatomy bcells lymph
-
What role do helper T cells play in B-cell activation?
They activate B cells and stimulate them using interleukin.
immunology thcells cytokines -
What happens to B cells that bind an antigen during the primary immune response?
They become activated and can differentiate into plasma B cells that produce antibodies.
immunology primary_response plasmacells -
How is antibody mRNA processed before translation?
The mRNA uses only part of the gene through post-transcriptional processing.
molecular_biology antibodies mrna -
Do all B cells express the same antibody genes?
No — some B cells with certain genetic makeup do not express some genes in the same way.
genetics bcells expression -
What interactions are illustrated in the lymph node diagram?

B cells interact with antigen presented by APCs and are influenced/activated by helper T cells (helper T stimulates B cells with interleukin).
diagram bcells thcells -
In clonal selection, what occurs when B-cells encounter antigens?
- One type of B-cell binds the antigen
immunology bcells clonalselection -
immunology bcells adaptive
-
immunology bcells clonalselection
-
immunology clonalselection bcells
-
cellbiology mitosis
-
immunology bcells adaptive
-
In clonal selection, what do antigen-recognizing B-cells become?
They become antibody-making plasma B cells.
immunology clonalselection plasmacells -
What is the role of B-cells in the adaptive immune response?
B-cells respond to a specific antigen by producing antigen-specific antibodies.
immunology bcells adaptive -
What does 'clonal selection' lead to in B-cell activation?
Clonal selection leads to production of large numbers of antibodies specific to the antigen.
immunology clonal_selection bcells -
bcells plasmacell antibodies
-
antibodies pathogens immunology
-
immunology bcells antibodies
-
immunology bcells lifespan
-
How do neutralizing antibodies affect SARS-CoV-2 entry into human cells?
- They block the viral spike protein from binding the ACE2 receptor, preventing the virus from sticking to the cell.
 antibodies neutralization virology
antibodies neutralization virology -
Give an example of an image that illustrates an antibody effect mentioned in the notes.
- SARS-CoV-2 virus particle
 images sarscov2 antibodies
images sarscov2 antibodies -
immunology bcell antibodies
-
immunology bcell lifespan
-
What is agglutination as an effect of antibodies?
- Sticking (clumping) of pathogens together, forming piles of pathogens
immunology antibodies agglutination -
How do antibodies reduce bacterial infection according to the notes?
- Prevent bacteria from entering or infecting cells and keep them in the fluid so macrophages can remove agglutinated bacteria
 immunology antibodies macrophage
immunology antibodies macrophage -
immunology lifespan bcells
-
What effect do antibodies have on free-floating antigens? (see diagram)
- Bind to free-floating antigens
 antibodies antigen mechanism
antibodies antigen mechanism -
What does precipitation by antibodies cause to happen to antigen molecules?
- Antigen molecules fall out of solution (precipitate)
antibodies precipitation antigen -
After antibodies cause antigen precipitation, how are the antigen complexes cleared?
- Cleared by macrophages
clearance macrophages immunity -
immunology antibodies macrophage
-
One effect of antibodies on pathogens is to attract which immune component?
They attract the complement system.
antibodies complement -
What happens to a bacterial cell when complement molecules form a pore in its membrane?
A pore causes cytoplasm to leak out and external fluids to leak in.
complement membrane pathogen -
immunology memory
-
immunology memory
-
Compared to plasma B cells, how long do memory B-cells live?
- Memory B-cells live longer than Plasma B cells
immunology cells -
What is the typical immunity duration for measles and the reported percentage with memory B-cells?
- Measles: lifetime immunity; (96%) already have memory B Cells
immunity measles -
immunity polio
-
immunity mumps
-
What is the reported duration of immunity for tetanus and its percentage?
- Tetanus: > 13 years; (96%)
immunity tetanus -
immunity hepatitisb
-
What is the reported duration of immunity for rubella and its percentage?
- Rubella: > 15-20 years; (>90%)
immunity rubella -
What is the reported duration of immunity for papilloma virus and note about its data?
- Papilloma virus: > 8 years; recently introduced
immunity hpv -
What is the reported duration of immunity for cholera and its percentage?
- Cholera: 3-6 months; (80%)
immunity cholera -
What is the primary feature of the secondary immune response on re-exposure to the same antigen?
The secondary immune response allows a quick response when the antigen is encountered again.
immunity secondary_response -
How do memory B cells respond upon re-exposure to their specific antigen?
Memory B-cells respond by making many plasma B cells specific to that antigen.
bcells memory -
Compared with the primary response, how does antibody concentration change during the secondary immune response?
Antibody concentration rises faster and to higher levels during the secondary immune response.
antibodies kinetics -
What clinical advantage does a faster secondary immune response provide?
A faster secondary response can neutralize the antigen before the person feels sick.
clinical protection -
Use the graph to illustrate the difference between primary and secondary antibody responses.
Primary response: slower rise after first exposure; Secondary response: rapid, larger rise after re-exposure.
 graph visual
graph visual -
immune fetus
-
antibodies placenta
-
antibodies breastmilk
-
What is active immunity in an infant?
- Active immunity is when an infant begins to make their own antibodies.
 immunity active infant
immunity active infant -
vaccines immunology
-
What type of immune cells are produced after vaccination to provide long-term protection?
Memory B cells
immunology memory -
smallpox virology
-
smallpox history
-
What was the approximate duration and percent effectiveness of smallpox immunity noted?
4–5 years at about 95% effectiveness
smallpox immunity -
When was smallpox eradicated in the United States and worldwide?
- United States: 1972
- Worldwide: 1977
smallpox eradication -
smallpox symptoms image
-
What is a monoclonal antibody (MAb) as described in the notes?
A monoclonal antibody is an antibody artificially produced and mass-produced for a particular antigen.
immunology antibodies -
What is a primary therapeutic purpose of labeled monoclonal antibodies?
To deliver a chemical label to a particular cell type to target and kill cancer cells.
therapy cancer -
Name the three main categories of monoclonal antibody approaches listed.
- 1. Naked MAb
- 2. Immunoconjugates
- 3. Multistep Targeting
classification antibodies -
Give examples of mechanisms or agents associated with 'Naked MAb' from the notes.
- ADCC
- CDC
- Radionuclide
- Radioimmunoconjugate
- Cytokine / Immunocytokine
nakedmab mechanisms -
List examples of immunoconjugate approaches mentioned in the notes.
- Biotinylated radioactive ligand
- Streptavidin
- Bispecific MAb (links killer cell)
- Immunotoxin, Immunoliposome, scFv-enzyme (ADEPT), Prodrug/Drug
immunoconjugates therapies -
What illustration is provided as an example of antibody targeting in the media?
Diagram of monoclonal antibodies attacking a tumor cell:
 media diagram
media diagram -
What scan image is included showing an organ with antibody uptake?
A scan identifying the thyroid with uptake:
 imaging thyroid
imaging thyroid -
immunofluorescence microscopy
-
In secondary immunofluorescence, which antibody typically carries the fluorophore?
The secondary antibody typically carries the fluorophore.
 immunofluorescence antibodies
immunofluorescence antibodies -
immunofluorescence cellbiology
-
Give one example of an antibody type used as a reagent in immunofluorescence.
Monoclonal antibodies.
reagents antibodies -
fish hybridization
-
immunofluorescence technique microscopy
-
What does the micrograph depict in the provided image?
- Fluorescently labeled neurons and glial cells
 microscopy neurons glia
microscopy neurons glia -
Which phrase in the input refers to labeling different cell types for visualization?
- Stain cell types
histology stain -
Which phrase in the input describes the spatial arrangement of cells in three dimensions?
- 3D relationships between cells
cells spatial
Overview
A concise guide to pathogens, the body's nonspecific and specific defenses, key immune cells, vaccination and antibody-based therapies.
 Alt text: Far Side comic castle under siege.
Alt text: Far Side comic castle under siege.
I. The Enemy — Pathogens
- Pathogens: organisms or agents that cause disease (bacteria, viruses, protists, fungi, parasitic animals).
A. Bacteria
- Single-celled organisms; many are harmless or beneficial, some are pathogenic.
- Bacteria use host resources to reproduce rapidly when nutrients are unlimited.
- Exponential growth (doubling every 20 min): general formula:
- Number after time \(t\) minutes: \(\(N(t)=N_0\times 2^{t/20}\)\)
- Example: starting from one cell, after 24 h (\(t=1440\)): \(\(N=2^{72}\approx4.7\times10^{21}\)\)
 Alt text: Microscopic spherical and rod-shaped bacteria.
Alt text: Microscopic spherical and rod-shaped bacteria.
B. Viruses
- Obligate intracellular parasites; infect host cells to replicate.
- Example: HIV infects helper T cells, reducing immune function.
 Alt text: White blood cell infected by HIV particles.
Alt text: White blood cell infected by HIV particles.
C. Protists
- Single-celled eukaryotes; some are parasitic (e.g., trypanosomes cause sleeping sickness, plasmodium causes malaria).
 Alt text: Red blood cells with trypanosomes.
Alt text: Red blood cells with trypanosomes.
D. Fungi
- Often cause skin and mucous infections (e.g., ringworm, athlete's foot).
 Alt text: Fungal infection on a foot.
Alt text: Fungal infection on a foot.
E. Parasitic animals
- Ectoparasites (mites, chiggers) and helminths feed on host tissues or blood and can trigger immune and allergic responses.
 Alt text: Chigger bite and parasitic skin track.
Alt text: Chigger bite and parasitic skin track.
II. Defense Systems
Two tiers: nonspecific (innate) defenses that act broadly, and specific (adaptive) defenses that target particular pathogens.
A. Nonspecific (innate) defenses
1. Physical & chemical barriers
- Skin: intact, dead outer layer sheds microbes and prevents entry.
 Alt text: Cross-section of skin with surface microbes.
Alt text: Cross-section of skin with surface microbes.
- Mucus: lines respiratory and digestive tracts, traps microbes; swallowed mucus sends pathogens to stomach.
 Alt text: Mucus trapping bacteria.
Alt text: Mucus trapping bacteria.
- Tears: contain antimicrobial molecules and drain to the nasopharynx, helping clear microbes.
 Alt text: Lacrimal system diagram showing tear drainage.
Alt text: Lacrimal system diagram showing tear drainage.
- Stomach acid (HCl): destroys many ingested microbes before they reach the intestine.
 Alt text: Digestive tract diagram including stomach.
Alt text: Digestive tract diagram including stomach.
- Ear wax: traps particles and microbes in the external ear canal.
2. Phagocytic white blood cells
- Macrophages/neutrophils engulf pathogens into vesicles, secrete digestive enzymes, and present antigen fragments to the adaptive immune system.
 Alt text: Phagocyte engulfing bacteria.
Alt text: Phagocyte engulfing bacteria.
3. Inflammation
- Damaged cells release histamine and other signals, increasing blood vessel permeability so immune cells and fluid enter the tissue.
- Signs: heat, redness, swelling, pain; pus forms from dead cells and WBCs.
 Alt text: Diagram of inflammation with swelling and phagocytes.
Alt text: Diagram of inflammation with swelling and phagocytes.
4. Antimicrobial substances
- Interferons: signal neighboring cells of viral infection and activate killer cells.
- Complement: protein cascade that can form pores in pathogen membranes causing lysis.
 Alt text: Complement molecule forming a hole in a cell membrane.
Alt text: Complement molecule forming a hole in a cell membrane.
5. Fever
- Body temperature > 38°C (100°F) can speed immune reactions and inhibit some microbes; high fevers require medical attention.
 Alt text: Child checked for fever with thermometer.
Alt text: Child checked for fever with thermometer.
B. Specific (adaptive) defenses
- Recognize antigens (molecules on pathogen surfaces) and respond with targeted antibodies and cell-mediated actions.
 Alt text: Antigens on cell surface.
Alt text: Antigens on cell surface.
- Antibodies: Y-shaped proteins produced by B cells that bind specific antigens to neutralize pathogens, agglutinate them, precipitate antigens, attract phagocytes, or activate complement.
 Alt text: Antibody molecule with heavy and light chains labeled.
Alt text: Antibody molecule with heavy and light chains labeled.
III. The Lymphatic System
- Filters interstitial fluid through lymph nodes; macrophages and lymphocytes destroy pathogens and return fluid to circulation.
- Key components: lymph vessels, lymph nodes, spleen, tonsils, thymus.
 Alt text: Cross-section of a lymph node with arrows.
Alt text: Cross-section of a lymph node with arrows.
IV. Cellular Players & the Immune Response
1. Antigen presenting cells (APCs)
- Macrophages/dendritic cells engulf pathogens, process antigens, display fragments on their surface and secrete cytokines (e.g., interleukin-1) to activate helper T cells.
 Alt text: Macrophage presenting antigen to helper T cell.
Alt text: Macrophage presenting antigen to helper T cell.
2. T cells
- Helper T cells (CD4+): activated by APCs; secrete interleukins (e.g., IL-2) to stimulate B cells and cytotoxic T cells.
- Cytotoxic (Killer) T cells (CD8+): kill infected “self” cells by releasing perforin and granzymes, inducing lysis.
- Suppressor (Regulatory) T cells: downregulate immune responses when infection is controlled.
 Alt text: Cytotoxic T cell forming pores in target cell membrane.
Alt text: Cytotoxic T cell forming pores in target cell membrane.
3. B cells and antibodies
- Clonal selection: many B-cell variants exist; antigen selects the B cell with matching receptor, which proliferates and differentiates.
- Activation steps: antigen binding → helper T cell stimulation → clonal expansion → differentiation into plasma and memory B cells.
 Alt text: B cells dividing into clones.
Alt text: B cells dividing into clones.
- Plasma B cells: short-lived antibody factories (days); produce large quantities of specific antibodies.
-
Memory B cells: long-lived; allow rapid, amplified response on re-exposure.
-
Antibody functions: neutralization (block receptor binding), agglutination, precipitation, opsonization (attract phagocytes), complement activation.
 Alt text: Neutralizing antibody preventing virus binding to ACE2 receptor.
Alt text: Neutralizing antibody preventing virus binding to ACE2 receptor.
V. Immune Responses: Primary vs Secondary
- Primary response: first encounter; slower (days to weeks) while naive B/T cells expand and differentiate.
- Secondary response: re-exposure produces faster, stronger antibody production due to memory B/T cells; often prevents illness.
 Alt text: Graph of antibody levels during primary and secondary responses.
Alt text: Graph of antibody levels during primary and secondary responses.
VI. Immune System Development & Passive Immunity
- Passive immunity: short-term protection via maternal antibodies crossing the placenta (IgG) and via breast milk (IgA).
- Active immunity: when the individual makes their own antibodies after infection or vaccination.
 Alt text: Human fetus in utero.
Alt text: Human fetus in utero.
VII. Disease Prevention & Therapies
A. Vaccines
- Expose immune system to safe form of antigen (killed, attenuated, subunit) to create memory B and T cells without causing disease.
- Historical success: smallpox eradication via vaccination.
 Alt text: Historical smallpox skin lesions.
Alt text: Historical smallpox skin lesions.
B. Monoclonal antibodies & targeted therapies
- Monoclonal antibodies (mAbs): lab-made, identical antibodies that target a single antigen; can be used for diagnostics, targeted drug delivery, cancer therapy, or to neutralize pathogens.
 Alt text: Diagram of monoclonal antibodies and conjugates targeting a tumor cell.
Alt text: Diagram of monoclonal antibodies and conjugates targeting a tumor cell.
C. Immunofluorescence & diagnostics
- Fluorescently labeled antibodies help visualize antigens or infected cells in tissues and cell preparations.
 Alt text: Micrograph of cells stained with fluorescent markers.
Alt text: Micrograph of cells stained with fluorescent markers.
VIII. Practical Prevention Measures
- Barrier measures: hand hygiene, intact skin, masks to reduce droplet/aerosol spread.
- Masks reduce expelled droplets/aerosols from coughing and sneezing and protect vulnerable hosts.
- Seek medical care for high fevers, persistent infection signs, or severe inflammation.
Quick Study Tips
- Remember the three Rs for immune defense: Recognize (antigen) → Respond (cells/antibodies) → Remember (memory cells).
- Link cells to roles: Macrophage = APC, Helper T = coordinator, Cytotoxic T = kills infected cells, B (plasma) = antibody factory, Memory B/T = long-term protection.
- Use the doubling formula \(N(t)=N_0\times2^{t/20}\) to estimate bacterial growth under ideal conditions.





